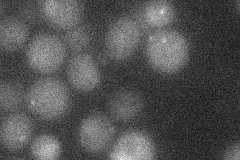
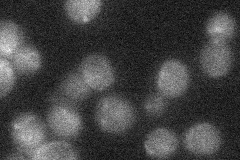

View description
Ubiquitin-protein ligase, involved in the proteasome-dependent degradation of aberrant nuclear proteins
Localization:
Intensity:
Fold change:
Significance:
-
C’ GFP library in SD

below threshold14.45 -
N' NOP1pr-GFP in SD

cytosol,nucleus24.9052 -
N' TEF2pr-mCherry in SD
punctate12.3345 -
N' NATIVEpr-GFP in SD
below threshold21.1753 -
N' TEF2pr-VC and Cyto-VN in SD

below threshold22.2447 -
C’ GFP library in SD+DTT

cytosol17.241.19No -
C’ GFP library in SD+H2O2

cytosol17.181.18No -
C’ GFP library in Starvation Media

cytosol15.031.03No -
C’ GFP library on the background of Pup2-DaMP

below threshold -
C’ GFP library on the background of CCT mutant

below threshold16.83311.1641No
